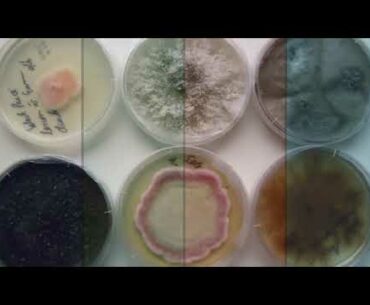
Do THIS To Your Vitamin C Before Eating To Protect Your Health | How To Boost Immune System Fast

Try Out Nano C For Yourself: Nano C Reviews: ———————————————————————- Nano C Review Nano C is a Vitamin C supplement like no other. It’s made using cutting-edge nanotechnology. And creates Vitamin C particles 1,000 times smaller than ordinary Vitamin C.…